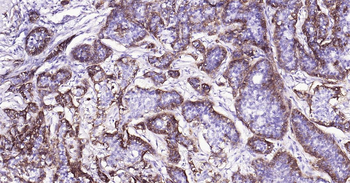
Human Integrin alpha 2 Ready-To-Use IHC Kit

You have no items in your shopping cart.
Search results for: 'Collagen'
- MMP3 Antibody / Matrix Metalloproteinase 3 [orb2643564]
ELISA, IHC-P
Human
Mouse
Monoclonal
Unconjugated
100 μg - Featured

- Collagen IV Antibody / COL4A1/2 [orb1151657]
IF, IHC-P, WB
Human
Mouse
Monoclonal
Unconjugated
20 μg, 100 μg - MMP3 Antibody / Matrix Metalloproteinase 3 [orb639812]
ELISA, IHC-P
Human
Mouse
Monoclonal
Unconjugated
100 μg, 20 μg Primate
0.16-10 ng/mL
0.057 ng/mL
48 T, 96 T